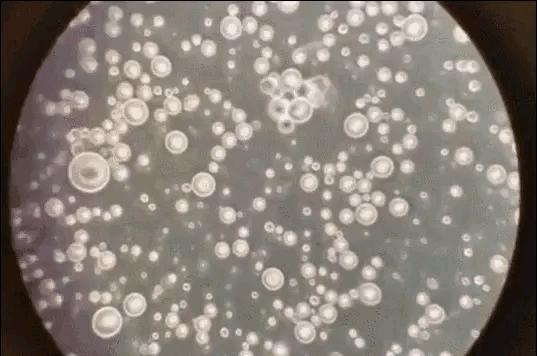
一张图读懂母乳和奶粉的区别,喂母乳和奶粉的宝宝有什么区别

文丨美妈很帅
小晴年轻的时候,为了提升自身的魅力,曾对胸部做过调整。生完宝宝后虽然母乳不少,但因为担心人工合成的假体对宝宝有影响,所以不敢母乳喂养,退而选择配方奶粉喂养。生完宝宝半年后约发小阿枢出来一起到儿童公园玩,看着两个同岁同月同日生的宝宝显示出来的差距不免感慨万千。两个宝宝,一个全母乳喂养,一个全奶粉喂养,果然还是有些差异啊。

小晴认真比对一下,发现自家宝宝虽然胖大一些,但一捏宝宝的肉感觉松垮垮的;阿枢家的宝宝虽然看起来比较清瘦,但一捏他的肉非常结实。听阿枢说她家的宝宝半年从没生过病,然而自家的宝宝已经生病三四次了,每次生病都弄得她精疲力尽。小晴跟我聊起这个话题,不免有些失落,她认为两个宝宝显示出来的差异,应该是母乳喂养与奶粉喂养造成的。

显微镜下的奶粉
那么母乳跟奶粉到底有什么区别呢?
母乳营养更丰富
虽然不少奶粉厂商标榜自己的生产的奶粉无限接近母乳,但母乳的营养,但是母乳是奶粉无法复制的。母乳拥有生物活性因子、活细胞,比奶粉拥有更多恰到好处的维生素与矿物质。曾有网友用显微镜将母乳放大1000倍后进行观察,发现母乳的纯度特别高,几乎没任何杂质,大小不一的圆形颗粒规律分布,微微抖动;而奶粉就显得十分死板,不但纯度较低,也不见“活物”,没有母乳中所含的活性细胞。就营养种类来说,母乳就比奶粉多了一半不止(见图4)。
显微镜下的母乳
母乳可弹性调配
母乳最大的一个优点就是,它能随着宝宝的成长来调整自己的成分,可以说是专为宝宝打造的“私人定制”口粮。我家宝宝是32周+2天出生的,当时担心母乳质量比足月儿妈妈的要差,医生告诉我,“恰恰相反,非足月儿妈妈的母乳所含的能量及营养成分比普通母乳要高。”提前出生的宝宝,身体各项机能较差,母乳会自动调配更适合他们成长的母乳,比如总能量、蛋白质含量、钙、铁、钠等关键性营养物明显比普通母乳高(见图5)。

图4:奶粉与母乳营养成分的比较
宝宝刚出生时,还没适应新的环境,免疫力有限,吞咽及吸食能力还没上来,只能吃少量的母乳,母乳也会自行调配,为宝宝提供更多免疫物质及其他营养素——这便是被称为“黄金液”的初乳。当宝宝进入猛涨期,奶量需求增加,也能够在1-2天内产生更多的乳汁。随着宝宝月龄的增加,抵抗力逐步增强,母乳会减少免疫物质,自行调配适合宝宝成长的最佳成分。
而奶粉,它的营养成分是恒定不变的,不像母乳那样智慧,会跟随宝宝的成长需要自行调配。

图5
母乳能增进亲子感情,强化宝宝智能
母乳中含有不少脂肪DHA与ARA(花生四烯酸),这些营养物质能强化宝宝的智能,促进视觉发展,而且在寻找奶源的过程中也需要动脑。在母乳喂哺过程中,将宝宝抱在温暖的怀里,宝宝会得到爱抚,能增强宝宝的安全感,建立更密切的亲子关系。
为啥吃奶粉的宝宝多半比吃母乳的要胖大?
细心的人会发现,吃奶粉的宝宝一般比吃母乳的显得胖大一丢丢,但身体却不如吃母乳宝宝那么结实。这是由于母乳中含有瘦素,这种物质能促使能量释放,抑制脂肪细胞的合成;母乳含有不少解脂酶,有利于脂肪消化吸收;而且母乳中还含有消化酶,蛋白也更容易被宝宝吸收。这些物质都能帮助宝宝消化吸收,保持适宜的体重,而奶粉却几乎没有这些物质。再者,吃母乳的宝宝吃奶时需要扭头寻找奶源,能锻炼颈部肌肉,吸食时尤其是刚刚吸的时候需要消耗较多的体力,而吃奶粉的宝宝都是泡好直接拿到嘴里吸,消耗的能量更小,自然发胖的几率相对较高。

诚然,母乳喂养的优势比奶粉喂养更多,也更智慧更理想,但人终究不是机器,不是一设定“程序”就能启动,每个妈妈的体质及所处的环境都不一样,有些人即使怎么努力也无法实现全母乳喂养,所以奶粉的存在自然有它的道理。我们不要从一个极端走向另一个极端,不能因为别人给宝宝吃奶粉就站在高处指责别人,要知道天下父母都是爱自己宝宝的,不管是花钱买奶粉的妈妈还是当奶牛的宝宝,都一样伟大!

关注我@美妈很帅,您将获得更多的有趣实用的育儿知识!